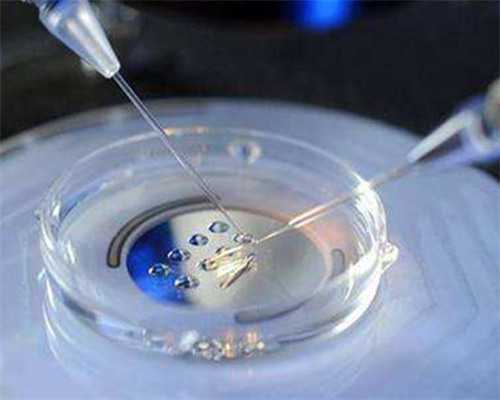
宠文：《团宠：暴躁大佬三岁半》，剧情不俗值得入坑，五星强推！_425R8

好多人对于三代试管技术的了解,都来源于自己的想象和他人的描述,也因此产生了许多不正确的观点,这些观点在不同的人之间辗转,导致有些人发现自己是不孕不育的一分子,也不敢去接触辅助生殖技术,其实是时候要重新认识一下三代试管技术了。
三代试管技术,既包含一二代技术的分别针对女性不孕和男性不育的特性,又多了一个遗传物质筛查技术,因此它既适合普通情况下不孕不育的家庭,又适合因为遗传疾病无法生育的家庭,另外高龄染色体变异易发的人群,也同样适合做三代试管。
三代试管技术之整个孕期都要打针吃药?
这是一些对试管过程不了解的人编造的发言,其实试管的过程只存在于妊娠以前,也就是说三代试管技术的重点在于帮助试管女性怀上宝宝,而不是整个妊娠期,基本上通过三代试管怀上宝宝以后,试管就相当于成功了。因此,孕期中的打针吃药是孕妇需要进行保胎或者别的治疗时医生安排的,而不是因为三代试管,这一点基本每个孕妇都是这样的。而三代试管的打针吃药几乎只集中在促排期,并且也不是每天都要,基本是隔天才进行。
三代试管技术之做试管宝宝会很痛?
目前三代试管宝宝的过程除了促排期间的针剂,基本没什么会产生痛感的项目,取卵时医生会安排半麻或者全麻,移植是没有痛感的,基本
10
多分钟就能完成。所以试管的过程对于一般的女性来说疼痛值是不高的,可以无需太担心。
三代试管技术之做了就能成功?
虽然目前的三代试管成功率较高,但并不代表每个人都能一次成功,能否移植一次成功,要看囊胚的质量、试管女性的身体状况和试管中心、试管医生的专业性,影响成功率的因素非常多,因此谁也不能保证成功率的哦。不过三代试管已经是辅助生殖的有效手段了,它的高成功率也吸引了许多不孕不育家庭,如果大家想要尽早成功,在试管前进行对身体的充分调理也是有必要的哦。
了解完上面的内容以后,是不是对三代试管有了更深层次的认知呢?如果还有相关的疑问,可以随时向我提问哦!
最近真的书荒了好久了,然后就发现了下面的几本小说,我还没看完觉得好看就上来给大家分享一下,都是我个人感觉好看的文文哦!如果觉得好看的话记得收藏一下哈,以后就不怕再书荒了!下面小编给大家推荐:
宠文:《团宠:暴躁大佬三岁半》,剧情不俗值得入坑,五星强推!>《妈咪今天又挣钱了呢》
简介:深爱的丈夫在外面找起了小三,一天换一个,一周不重样!隔天还要拿着B超单到她面前炫耀:南浅,你生不出孩子,自然有别人帮我生!靠!什么垃圾男人,她不要了!她要花光他的钱,让那个狗男人去喝西北风!可是怎么办呢?
入坑指南:六年…… 她和陆瑾行的婚姻,终于走到了绝境。 滴。 南浅的手机震颤了一下。 是陆瑾行的短信:【离婚协议,我草拟好了,你回来签一下。按照约定,我净身出户】。 南浅懵了一下,然后转头就给直属上级秦老拨了电话:“老师,早上的事,我重新考虑了一下,我觉得我可 以。”
“浅浅,这次的任务很艰险,成功率不到万分之一。【长生】的运行轨道一直在变,你很有可能会和你的父 母一样,迷失在外太空……”“老师,我想得很清楚。国家的事,科研的事,一刻都耽误不了的!如果可以的话,我申请立刻登船!如果 我爸爸妈妈爷爷都还在的话,他们也一定会支持我!” 支持我逃离陆瑾行! 支持我逃离这该死的婚姻坟墓!
电话那头,秦老深吸了一口气:“浅浅,你是老师的骄傲,也是祖国的骄傲!” 一个小时后。 南浅穿好宇航服,做好一切准备,踏入舱门之前,从耳朵上摘下一对珍珠耳钉,递到秦老手里,道:“老 师,麻烦你帮我转交陆瑾行。” 秦越神情一震:“阿行好歹是你丈夫,上飞船之前,你不给他打个电话?” “不了。” 南浅浅浅一笑,“老师,你知道的。阿行那么疼我,要是给他打了电话,我还能登船吗?”
“也是。”秦老握紧了那对耳钉,心里内疚不已。 合上太空头盔的瞬间,南浅将早已编辑好的短信发了出去。 ——【陆瑾行,再见!陆瑾行,祝你和你的楚冰冰,白头到老,早生贵子!】
(点击下方免费阅读)
《明明是你先动心》
简介:
“妈咪,为什么我和爸爸长得不一样啊?”某团子问道。“……”乔苒。“妈咪,为什么那个叔叔和我长得好像啊?”某团子问道。“……”乔苒。“妈咪,为什么这个叔叔叫我儿子?”某团子问道。“……”乔苒。“妈咪,为什么……”
入坑指南:长长的头发垂下,连带着泪水遮住了她大半张脸,此时的乔苒怀里抱着酒瓶子,可谓十分狼狈。闻川开车路过的时候,一时间以为是自己眼花了。将车子停下,听着女人絮絮叨叨的哭诉,眉宇之间带着倦色。“张逸你无耻,不行的是你,不会生的也是你,同意试管的是你,嫌弃儿子不是自己的还是你。“ “为什么所有的事情都得你满意才行,为什么最后把所有的错都怪在我的身上。我乔苒也是有心的,也会疼。”
像要把所有的痛苦都宣泄出来,乔苒摇摇晃晃地起身,指着自己心脏的位置,对着空气说:“你知不知道,你每一次对昀儿的冷落我这里就心疼一次。你嘴上说着爱我,背地里却抱着别的女人,我的心也疼一次。”“你每次都认真认错,却从来不会悔过。你就是一个伪君子,无耻之徒。”
夏日的夜闷热,加上骂的累了,乔苒伸手扯开衬衣领子,这个举动被闻川看到还以为她要做出过分的事,连忙走上前禁锢住对方的手。“你大晚上不回家在这撒酒疯?”“嗯?”沾着泪水的眼睛朦胧,乔苒有些不确定眼前这人是谁。“哪来的臭男人,放开我。”“闻川。”对方一本正经地回答,视线内是女人红彤彤的脸颊,微开的领口露出白皙的脖子,上面挂着一条精细的白金项链。“闻……川,我认识你,你是文德高中的传奇,我的偶像。”
凑近几分看清对方,乔苒的手触碰到男人的下巴后略显轻挑地勾唇道:“学长,你长得可真帅。” “是吗?”男人挑眉,将乔苒塞进后座然而俯身过去,“车里凉快,给你时间慢慢欣赏我这个……偶像。”他不是多管闲事的人,只是眼前的女人有些特殊,让他不得不顾着她的安危。放大的脸庞让乔苒有些恍惚,待嗅到一股酒味后伸手推开了面前的人,嘟囔道:“你这个出租车司机居然酒驾,信不信我投诉你。”得,方才还以为她有些清醒,这会看来是真醉了。
(点击下方免费阅读)
《
团宠:暴躁大佬三岁半
》
简介:宠文:《团宠:暴躁大佬三岁半》,剧情不俗值得入坑,五星强推!>身为地下暗网头目之一的曾甜,因凑热闹而身中流弹身亡。 倒下之前内心只有一句话:凑热闹死得快… 当她再次醒来时,简直欲哭无泪… 穿越重生类小说她看过不少,但到她这里怎么就成个小娃娃了? 就这小胳膊小腿,让她怎么去实现她那宏图大业!
入坑指南:在车上曾烨还问着自己女儿:“糖糖是怎么知道照着膝盖踹的呢?”这个问题他真的想不明白,按道理说,他们家也没有跟她讲过人体的脆弱点啊,这孩子是怎么知道的? 曾甜假装不懂的回复道:“我看电视里是这么说的啊~” 这下喻卉也来精神了:“是什么什么电视节目?”下次坚决不看。
“就和妈妈一起看的电视剧呀,就人可以在天上飞的那个,还有点穴什么的~” 喻卉扶额对着自家老公说道:“最近糖糖和我在家又看仙侠剧。”这下曾烨懂了,原来是电视剧里人物打斗的场景,被曾甜记了下来,没想到误打误撞用上了,并且还成功了;看来下次在家里看电视剧得躲着看了。 最终的结果,曾甜的第一天幼儿园生活,只待了半天,却以打架宣布告终。
曾烨这下是真没辙了:“你妹妹的家教都是退伍的军人,上次去祖宅接糖糖回家时,就看见她在练习枪法。” 曾明轩翻动书页的手,顿时停了下来,抬起头不敢置信的盯着曾烨看去,甚至心里还窜起一股无名火。 “糖糖才三岁半!为什么要她学这个!” “你们是不是都糊涂了!”
曾烨叹了口气,他当然知道这个事情挺让人难以接受的,但这的确也是真在发生的一切。 “明轩,有些事爸爸不知道该怎么跟你说,但你记住一点,我们家没有人会强迫糖糖做任何事。”
(点击下方免费阅读)
今天的推荐就到这里啦,大家有什么好看的小说也可以在文末下方留言区告诉小编哦,或者有什么建议也可以在下方联系哦,小编就能看到哦,期待你的留言~

|
| 代怀产子价格_40多岁代孕_3TkIa_86065_5e9Oy_孕初期白带偏黄伴有炎症,可以使用甲 |

|
| AA69助孕中心_什么叫借卵生子_昆山供卵试管地址 昆山中医院试管做试管婴儿要 |

|
| 中信湘雅试管供卵_AA69助孕中心_东莞供卵试管首选网站 东莞试管婴儿多久成功 |

|
| 怀孕备孕生男生女都要做孕前检查,准爸爸备孕要做的检查全在这里 |

|
| 试管婴儿或者代孕的孕妈妈为什么会去做亲子鉴定? |

|
| 合肥代孕的合法性 安徽合肥做供卵试管婴儿医院有哪些? ‘双顶径22和股骨长 |
